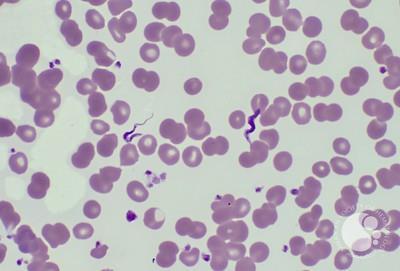
<ol><li><p>is this a protist or a bacteria?</p></li><li><p>what phylum?</p></li><li><p>what disease does this cause?</p></li></ol><p></p>
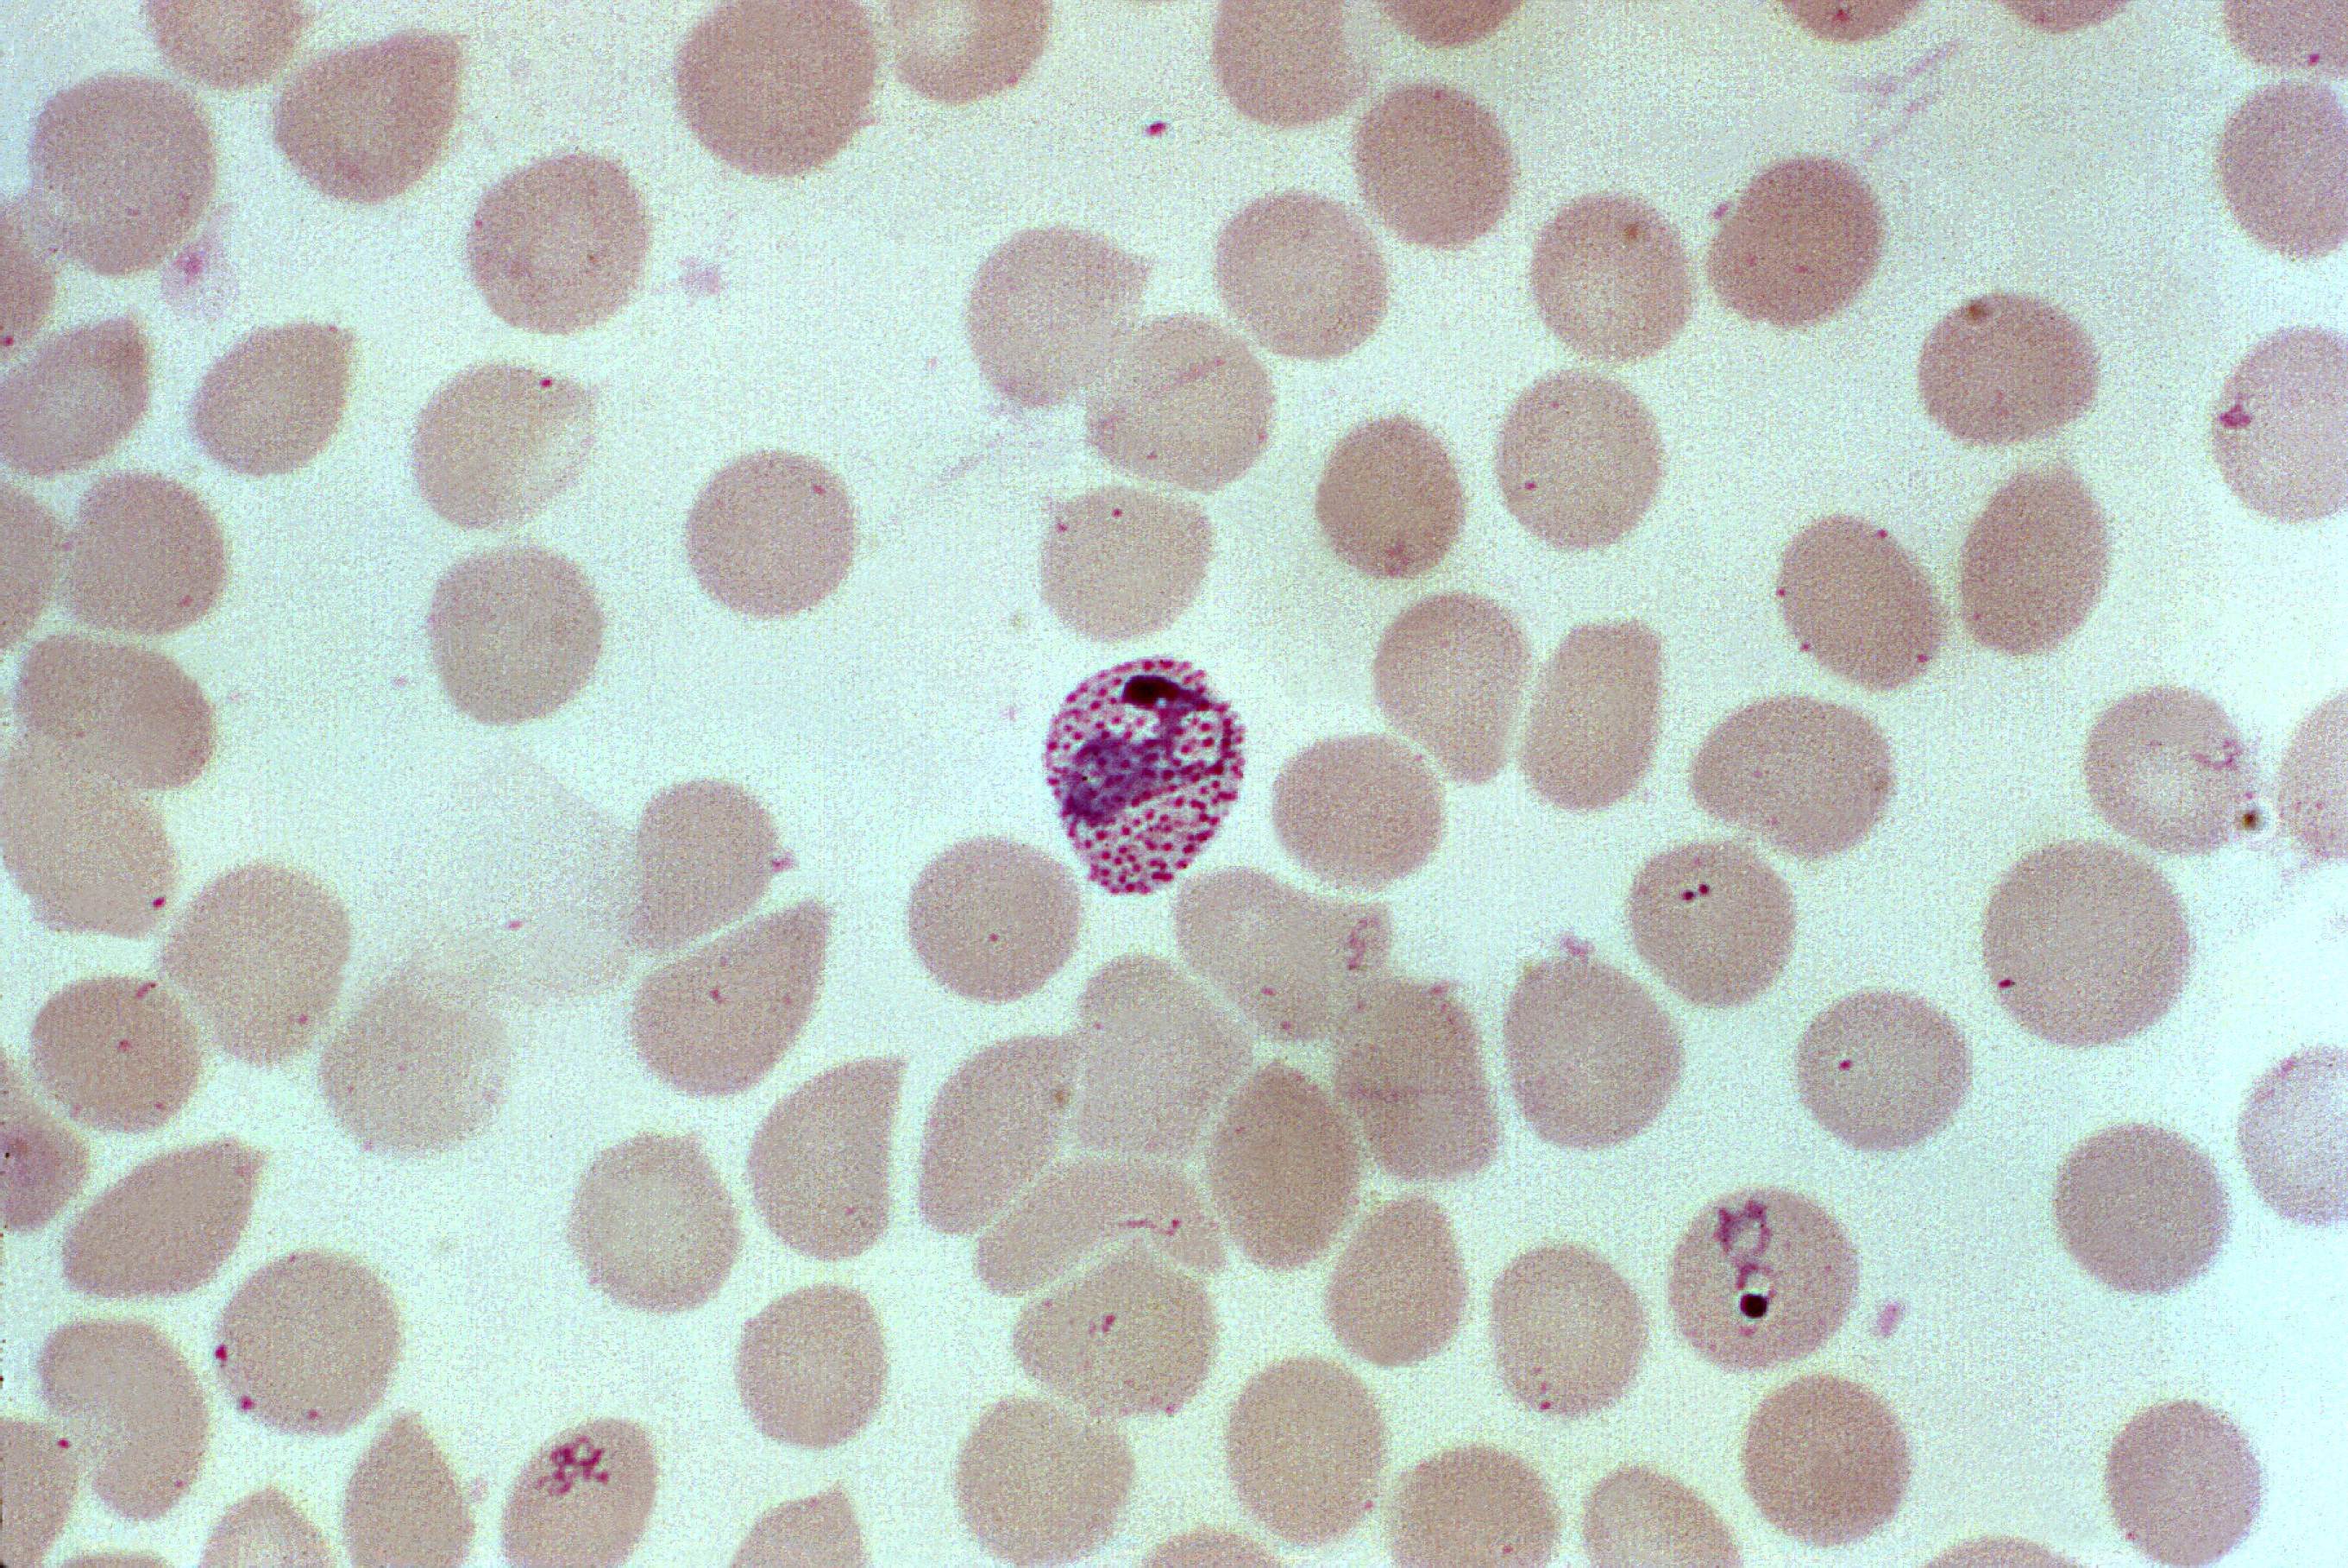
<ol><li><p>is this a protist or a bacteria?</p></li><li><p>what phylum?</p></li><li><p>what disease does this cause?</p></li><li><p>what is this structure called (the one in the center)?</p></li></ol><p></p>

1/47
San Diego Miramar College Lab Exam #1 Biology 210B
Name | Mastery | Learn | Test | Matching | Spaced | Call with Kai |
|---|
No analytics yet
Send a link to your students to track their progress

what phylum is this bacteria?
is it gram positive or gram negative?
proteobacteria
gram negative

what phylum is this bacteria?
is it gram positive or gram negative?
firmicutes
gram positive

what is the phylum of this bacteria?
is it gram positive or gram negative?
what is the name of the specialized cell on the organism that fixates nitrogen?
cyanobacteria
gram negative
heterocyst

what is the phylum of this bacteria?
gram positive or gram negative?
cyanobacteria
gram negative

is this a protist or a bacteria?
what phylum is this?
what species is this species mutualistic with?
protist
parabasalids
termites

is this a bacteria or a protist?
what phylum?
protist
euglenozoa
is this a protist or a bacteria?
what phylum?
what disease does this cause?
protist
kinetoplastid
african sleeping sickness

is this a protist or a bacteria?
what phylum?
what is their exterior made out of?
protist
dinoflagellata
cellulose
is this a protist or a bacteria?
what phylum?
what disease does this cause?
what is this structure called (the one in the center)?
protist
apicomplexa
malaria
trophozoite

is this a protist or a bacteria?
what phylum?
what are the hair like structures?
protist
ciliophora
cilia

is this a protist or a bacteria?
what phylum?
what is this species called?
protist
ciliophora
vorticella

is this a protist or a bacteria?
what phylum?
what is the shell made of?
protist
heterokontophyta
silica

what class is this organism?
what is the ploidy?
what is the common name?
phaceophycae
2n
brown algae

what is the phylum?
what is the shell made out of?
what structure would come out of the pores?
foraminifera
calcium carbonate
pseudopodia

what is the phylum?
what are they made of?
do they have pseudopodia?
radiolaria
silica
yes

what phylum?
what is the common name?
rhodophyta
red algae

what is the phylum?
what are these organisms called?
chlorophyta
desmids

what is the phylum?
how do they reproduce?
spirogyra
conjugation

what is the phylum?
what process is being shown?
spirogyra
conjugation

what is the phylum?
is it a single organism or a colony?
chlorophyta
colony

what is the phylum?
does this organism have pseudopodia?
amoebozoa
yes

what is the phylum?
what is the ploidy of the orange?
what is the ploidy of the green?
bryophyta
2n
n

what is the phylum?
is this an archegonium or an antheridium?
what is the ploidy?
bryophyta
archegonium
n

what is the phylum?
is this an archegonium or an antheridium?
what is the ploidy?
bryophyta
antheridium
n

what is the phylum?
what structure is this?
what is the ploidy of the capsule?
what are the ploidy of the spores?
bryophyta
sporophyte
2n
n

what is the phylum?
is this an archegonium or an antheridium?
what is the ploidy of the structure?
hepatophyta
archegonium
n

what is the phylum?
is this an archegonium or an antheridium?
what is the ploidy of the structure?
hepatophyta
antheridium
n

what is the phylum?
what is this structure?
what is the ploidy of the big sacks?
what are the ploidy of the spores?
hepatophyta
sporophyte
2n
n

what is the phylum?
what is the structure on the left?
what is the structure on the right?
what is the ploidy of the structure on the left?
what is the ploidy of the structure on the right?
lycophyta
megasporangium
microsporangium
2n
2n

what is the name of this organism?
resurrection fern

what is the phylum?
what is the structure at the end?
what is the ploidy of the structure at the end?
what is the ploidy of the green stem?
monilophyta
strobilus
n
2n

what is the phylum?
what is the structure?
what are the spherical structures in the bottom half?
monilophyta
sorus
sporangium

what is the phylum?
what is the structure?
what are the dark dots?
monilophyta
prothallus
antheridia

what is the phylum?
what is the structure?
what is the ploidy of the dots inside the wing/leaf looking things?
coniferophyta
staminate cone
n

what is this structure?
what is the ploidy?
what is the ring inside?
pollen
n
tube nucleus

what is the phylum?
what is the structure?
what is the ploidy?
coniferophyta
ovulate cone
2n

what is this?
what is the ploidy?
pine seed
2n

is this an angiosperm or a gymnosperm?
what structure is this?
what is the ploidy?
angiosperm
anther
2n, except microspores are n

what is the structure?
what is the ploidy?
what are the red circles inside?
ovary
2n
ovules

what is this structure?
what is the zone on the bottom half?
what is the zone on the upper half?
root tip
zone of division
zone of elongation

what is this structure?
what are the two structures making a tear drop shape at the top?
what are the two structures spanning out beyond the frame?
what are the two structures sitting above the structure spanning out beyond the frame in red?
what is the structure sitting inside the tear drop shape?
stem tip
young leaves
old leaves
axillary buds
apical bud

is this a eudicot or monocot?
what structure is this?
what is the dip in the structure?
monocot
leaf
stomata

is this a eudicot or a monocot?
what structure is this?
what are the red long lines going through?
eudicot
leaf
parenchyma

is this a monocot or a eudicot?
what structure is this?
what are the circles inside?
monocot
stem
vascular bundles

is this a eudicot or a monocot?
what structure is this?
what type of cell is red facing outward on the inside of the structure?
eudicot
stem
sclerenchyma

what is this a cross section of?
what is the dark ring on the outside?
what is the open ring on the inside?
woody dicot stem
cork
pith

is this a monocot or a dicot?
what is this structure?
what are the big circular holes?
monocot
root
xylem

is this a monocot or a eudicot?
what structure is this?
what is the center made out of?
eudicot
root
xylem and phloem